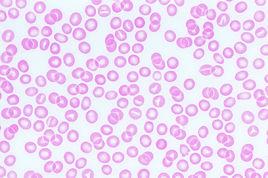
血塗片

方法
血塗片
瑞氏染色法原理
1. 瑞氏染料是由酸性染料伊紅和鹼性染料美藍組成的複合染料。
血塗片美藍(又名亞甲藍mehyleneblue)為四甲基硫堇染料,有對醌型和鄰醌型兩種結構,通常為氯鹽,即氯化美藍,美藍容易氧化為一,二,三甲基硫堇等次級染料(即天青)市售美藍中部份已被氧化為天青.伊紅(又名曙紅cosin)通常為鈉鹽即伊紅化鈉。美藍和伊紅水溶液混合後產生一種憎液性膠體伊紅化美藍中性沉澱,即瑞氏染料。瑞氏染料溶於甲醇後,又重新解離為帶正電的美藍和帶負電的伊紅離子。2.細胞的染色既有物理的吸附作用又有化學的親和作用.各種細胞和細胞的各種成份化學性質不同對各種染色料的親和力也不一樣.因此用染色液染色後在同一血片上可以看到各種不同的色彩,例如血紅蛋白嗜酸性顆粒為鹼性蛋白質與酸性染料伊紅結合染粉紅色稱為酸性物質,細胞核蛋白和淋巴細胞漿為酸性,與鹼性染料美藍或天青結合,染藍色或紫色稱為嗜鹼性物質,中性顆粒成等電狀態與伊紅和美藍均可結合,染紫紅色稱中性物質.
實驗材料
3.1實驗材料:醫用採血針、酒精棉球、載玻片、血推片、消毒牙籤
3.2實驗試劑:瑞氏染液、抗B血清、抗A血清、生理鹽水、蒸餾水
3.3儀器設備:Motic光學顯微鏡
實驗步驟
4.1ABO血型鑑定
4.1.1取一塊清潔玻片,用記號筆標上記號。
4.1.2用小滴管吸A型標準血清(抗B)一滴加入左側,用另一小滴管吸B型標準血清(抗A)一滴加入右側
4.1.3以穿刺法自左手無名指指尖取血,在玻片的每側各放入一小滴血,用牙籤攪拌,使每側抗血清和血液混和。每邊用一支牙籤,切勿混用。
4.1.4靜置室溫下10—15min後,觀察有無凝集現象,並據此判斷血型。
4.2血塗片的製作及血細胞觀察
4.2.1取末捎血一滴置於玻片的一端,左手持載玻片,右手以邊緣平滑的推片的一端從血滴前方後移接觸血滴,血滴即沿推片散開。然後便推片與載片夾角保持30-45度平穩地向前移動,載片上保留下一薄層血膜
4.2.2血塗片製成後可手持玻片在空氣中揮動,使血膜迅速乾燥,以免血細胞皺縮.
4.2.3用蠟筆在血膜兩側劃線,以防染液溢出,然後將血膜平放在染色架上.加瑞氏染液2-3滴,使覆蓋整個血膜,固定0.5-1.0分鐘.滴加等量或稍多的新鮮蒸餾水,與染料混勻染色5-10分鐘.
4.2.4用清水衝去染液,待自然乾燥後或用吸水紙吸乾,即可置血塗片於顯微鏡下進行鏡檢。
4.2.5白細胞分類計數。
選擇塗片的體尾交界處染色良好的區域,在油鏡下計數100個紅細胞,按其形態特徵進行分類計數,求出各類細胞所占比值。
瑞氏染液:瑞氏染料1g加甲醇(AR)600ML。將瑞氏染料放在清潔乾燥乳缽中,加少量甲醇,充分研磨使染料溶解.將已完全溶解的部分倒入棕色試劑瓶中,未溶解部分再加少量甲醇研磨,直至染料完全溶解於甲醇為止。新配製的染料偏鹼,須在室溫和37℃下一定時間待染料成熟,主要美藍逐漸增多為天青B後才能使用.貯存時間越久染色效果越好,因此,Deamgilliland等採用吸光度比值(rA)作為瑞氏染料的質量規格.rA測定方法如下:取瑞氏染液15-25ul(視染液濃度而定)加甲醇10ml稀釋,混勻後以甲醇為空白管分別以波長650nm,525nm比色,rA=A650/A525。
因為美藍吸收峰為波長650nm,伊紅吸收峰波長為525nm,天青B吸收峰也為650nm,但吸光度A約為美藍的一半.所以新配製染料的RA接近2,隨著美藍逐漸氧化為天青B,RA也相應下降,RA下降達1.3±0.1即可使用.瑞氏染料在貯存過程中必須塞嚴,以防甲醇揮發和氧化為甲酸.有人主張配方中加入30ml甘油,防止甲酸揮發,並可使細胞染色清晰.甲醇必須純淨,如甲醇中丙酮含量過多,染色偏酸,使細胞著色不良。磷酸鹽緩衝液(PH6.4-6.8):磷酸二氫鉀0.3g加磷酸氫二鈉0.2g再加蒸餾水至1000ml,配製成磷酸鹽緩衝液調整PH,如無緩衝液可用新鮮蒸餾水代替。
1.瑞氏染液:瑞氏染料1g加甲醇(AR)600ML。將瑞氏染料放在清潔乾燥乳缽中,加少量甲醇,充分研磨使染料溶解.將已完全溶解的部分倒入棕色試劑瓶中,未溶解部分再加少量甲醇研磨,直至染料完全溶解於甲醇為止。新配製的染料偏鹼,須在室溫和37℃下一定時間待染料成熟,主要美藍逐漸增多為天青B後才能使用.貯存時間越久染色效果越好,因此,Deamgilliland等採用吸光度比值(rA)作為瑞氏染料的質量規格.rA測定方法如下:取瑞氏染液15-25ul(視染液濃度而定)加甲醇10ml稀釋,混勻後以甲醇為空白管分別以波長650nm,525nm比色,rA=A650/A525。
因為美藍吸收峰為波長650nm,伊紅吸收峰波長為525nm,天青B吸收峰也為650nm,但吸光度A約為美藍的一半.所以新配製染料的RA接近2,隨著美藍逐漸氧化為天青B,RA也相應下降,RA下降達1.3±0.1即可使用.瑞氏染料在貯存過程中必須塞嚴,以防甲醇揮發和氧化為甲酸.有人主張配方中加入30ml甘油,防止甲酸揮發,並可使細胞染色清晰.甲醇必須純淨,如甲醇中丙酮含量過多,染色偏酸,使細胞著色不良。磷酸鹽緩衝液(PH6.4-6.8):磷酸二氫鉀0.3g加磷酸氫二鈉0.2g再加蒸餾水至1000ml,配製成磷酸鹽緩衝液調整PH,如無緩衝液可用新鮮蒸餾水代替。
正常參考值
細胞類別成人
桿狀核0.01-0.05
分葉核0.50-0.70
嗜酸性粒細胞0.005-0.05
嗜鹼性粒細胞0-0.01
淋巴細胞0.20-0.40
單核細胞0.03-0.08
附註
1要避免重複計數,玻片應由血膜邊緣向中央依次上下呈曲線移動.
2白細胞總數超過20×109/L,應分類計數200個細胞,白細胞數明顯減少的血片,可檢查多張血片。
注意事項
1) 玻片的清洗:新玻片常有游離鹼質,因此套用清洗液或10%鹽酸浸泡24小時,然後再徹底清洗。用過的玻片可放入適量肥皂水或合成洗滌劑的清水中煮沸20分鐘,再用熱水將肥皂和血膜洗去,用自來水反覆沖洗,必要時再置95%乙醇中浸泡1小時,然後擦乾或烤乾備用。使用玻片時只能手持玻片邊緣,切勿觸及玻片表面;,以保持玻片清潔,乾燥,中性、無油膩。
2) 細胞染色對氫離子濃度十分敏感,在染色過程中玻片必須化學清潔,配製瑞氏染液必須用優質甲醇,稀釋染液必須用緩衝液,沖洗用水應近中性,否則各種細胞染色反應異常,致使細胞的識別困難,甚至造成錯誤。
3) 一張良好的血片,要求厚薄適宜,頭體尾分明,分布均勻,邊緣整齊,兩側留有空隙。血片制好後最好立即固定染色,以免細胞溶解和發生退行性變。
4) 血膜未乾透,細胞尚未牢固附在玻片上,在染色過程中容易脫落,因此血膜必需充分乾燥.
5) 染色時間與染液濃度,室溫高低,細胞多少有關.染液越淡,室溫越低,細胞越多,所需染色時間越長或應適當增加染液量,因此染色時間應視具體情況而定.特別是更換新染料時必須經試染,摸索最佳染色條件.
6) 染液不可過少,以防蒸發乾燥染料沉著於血片上難沖洗乾淨.
7) 沖洗時套用流水將染液衝去.不能先倒掉染液,以免染料沉著於血片上.
8) 染色過深可用甲醇或酒精適當脫色,最好不復染,必須復染時,可將染液先稀釋好再復染.
9) 染色時應注意保護血膜尾部細胞,不能劃掉.因為體積較大細胞常在此處出現.
染色結果
在正常情況下血膜外觀為粉紅色,在顯微鏡下紅細胞呈肉紅色;白細胞胞漿能顯示各種細胞的特有色彩,細胞核染紫紅色,染色質清楚,粗細鬆緊可辨。染色結果偏酸,則紅細胞和嗜酸性粒細胞顆粒偏紅,白細胞核呈淺藍色或不著色;染色結果偏鹼,則所有細胞染成灰藍色,顆粒深暗,嗜酸性顆粒可染成暗褐色,甚至紫黑色或藍色。嗜中性顆粒偏粗,偏鹼(紫黑色).血片原處呈綠色.
提問添加摘要